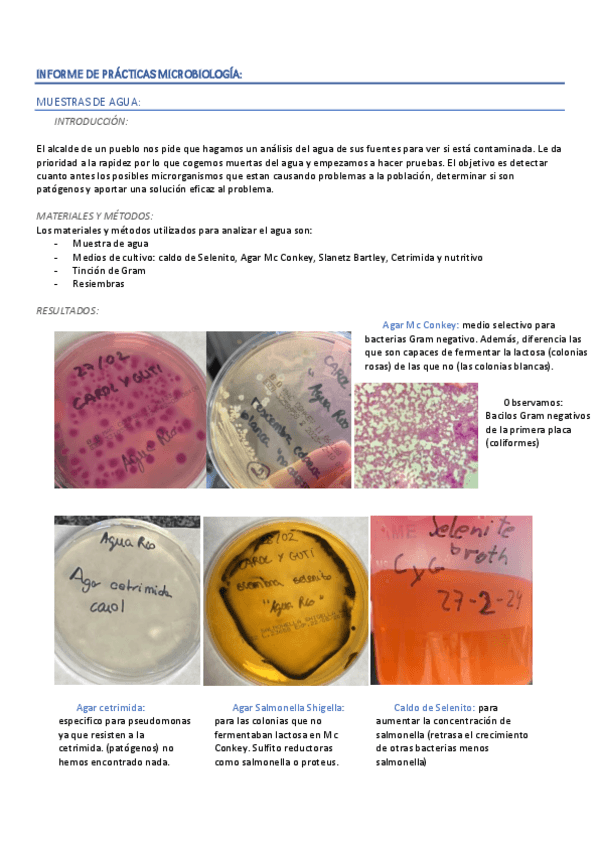

Microbiología
apuntes
-
Micro
He publicado nuevos apuntes de 2º Microbiología: Micro
He publicado nuevos practicas de 2º Microbiología: Apuntes-practicas-micro..pdf
He publicado nuevos practicas de 2º Microbiología: micro-cuaderno-practicas.pdf
He publicado nuevos apuntes de 2º Microbiología: TEMA-25-BIOTECNOLOGIA-MICROBIANA.pdf
He publicado nuevos apuntes de 2º Microbiología: TEMA-24-INTERACCIONES-ENTRE-MICROORGANISMOS.pdf
He publicado nuevos apuntes de 2º Microbiología: T.22-EXTREMOFILOS y T. 23-CICLOS-BIOGEOQUÍMICOS.pdf
He publicado nuevos apuntes de 2º Microbiología: TEMA-21-RELACIONES-HUESPED-PARASITO-EN-LAS-ENFERMEDADES-INFECCIOSAS.pdf
He publicado nuevos apuntes de 2º Microbiología: Tema-21-tabla-enfermedades.pdf
He publicado nuevos apuntes de 2º Microbiología: antibioticos-esquema.pdf
He publicado nuevos apuntes de 2º Microbiología: posibles-preguntas-micro.pdf
He publicado nuevos apuntes de 2º Microbiología: Antibioticos-esquema.pdf
He publicado nuevos apuntes de 2º Microbiología: Tablas-antibioticos.pdf
He publicado nuevos apuntes de 2º Microbiología: TEMA-17-19-Microbiologia.pdf
He publicado nuevos apuntes de 2º Microbiología: TEMA-11-15-Microbiologia.pdf
He publicado nuevos apuntes de 2º Microbiología: TEMA-6-10-Microbiologia.pdf
He publicado nuevos apuntes de 2º Microbiología: TEMAS-1-5-Microbiologia.pdf
He publicado nuevos apuntes de 2º Microbiología: Microbiologia-apts.pdf
practicas
-
Informes
He publicado nuevos practicas de 2º Microbiología: Informes
He publicado nuevos apuntes de 2º Microbiología: apuntes-primer-parcial.pdf
He publicado nuevos apuntes de 2º Microbiología: Informes-de-practicas.pdf
He publicado nuevos apuntes de 2º Microbiología: MIC-B1-B2-B3-B4-B5.pdf
He publicado nuevos apuntes de 2º Microbiología: Esquema-Plasmidos-y-recombinacion-bacterias.pdf
He publicado nuevos apuntes de 2º Microbiología: Esquema-Enfermedades-infecciosas.pdf
He publicado nuevos apuntes de 2º Microbiología: Esquema-Ciclos-biogeoquimicos.pdf
He publicado nuevos apuntes de 2º Microbiología: Esquema-Antibioticos-y-resistencia.pdf
He publicado nuevos apuntes de 2º Microbiología: MICROBIOLOGIA-Cosas.pdf
He publicado nuevos apuntes de 2º Microbiología: Trabajo-Noticia-sobre-algun-microorganismo.pdf
He publicado nuevos apuntes de 2º Microbiología: Trabajo-Proceso-de-esporulacion-bacteriana.pdf
apuntes
-
CURSO 20/21
He publicado nuevos apuntes de 2º Microbiología: CURSO 20/21
apuntes
-
Parcial
He publicado nuevos apuntes de 2º Microbiología: Parcial

¡Estás al día!
Has visto todos los archivos